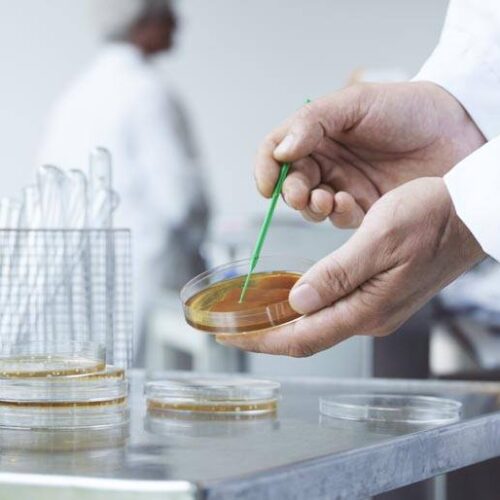

NIB in Denmark
NIB has been operating in Denmark since 1978, providing approximately EUR 10.0 billion (DKK 71 billion) in financing to more than 315 projects in the country.
Denmark founded NIB together with the other Nordic countries in 1975. Some of NIB’s latest financed projects in the country include the expansion of KK Wind Solutions, fibre rollout investments and a sustainability-linked loan to FLSmitdth.
NIB financing in Denmark has been broad-based, encompassing themes such as electrification, sustainable energy, digitalisation, life sciences, consumer goods and services, and food, leveraging our expertise in these domains.
Looking ahead, NIB aims to continue to support economic growth, the green transition and bolster key value chains and technologies.
| Member country | Credit rating* | Authorised capital | Country's share |
|---|---|---|---|
| Denmark | Aaa/AAA | 1,763,074,493.79€ | 21.1% |
| Estonia | A1 | 76,651,259.81€ | 0.9% |
| Finland | Aa1/AA+ | 1,482,690,785.19€ | 17.7% |
| Iceland | A1/A+ | 79,132,913.42€ | 0.9% |
| Latvia | A3/A | 111,830,807.21€ | 1.3% |
| Lithuania | A2/A | 163,231,714.80€ | 2.0% |
| Norway | Aaa/AAA | 1,799,704,941.30€ | 21.5% |
| Sweden | Aaa/AAA | 2,892,527,558.59€ | 34.6% |
| Total | 8,368,844,474.11€ | 100.0% |